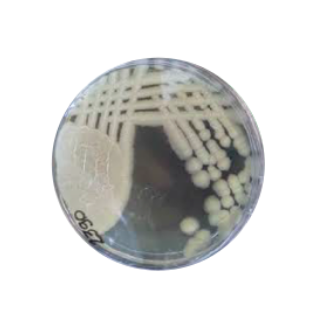
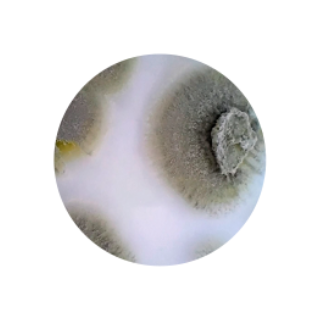
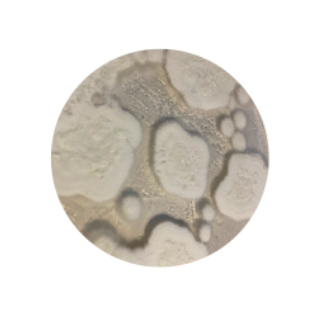

BLEND SECT
Entomopatogênico & biotóxico
▶ Vídeo do blend SECT
Bacillus thuringiensis (Bt)
Bacillus thuringiensis (Bt)
- Toxinas Cry — foco em lagartas e alguns coleópteros.
Metarhizium anisopliae
Metarhizium anisopliae
- Fungo entomopatogênico — penetração por contato.
Ss Saccharopolyspora spinosa
- Espinosinas (neurotoxinas) — ingestão/contato.

Beauveria bassiana
Beauveria bassiana
 Isaria fumosorosea
Isaria fumosorosea